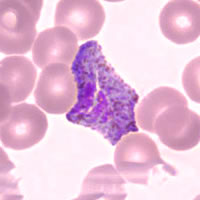
Case 64 Image A
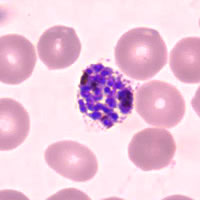
Case 64 Image C

Answer
to Case 64
This was a case of malaria caused by a Plasmodium species other than
P. falciparum. The gametocytes shown in Figure A appeared
large and round (which suggests P. vivax or P. ovale).
The rings shown in Figure B had large chromatin masses and the
schizont shown in Figure C had about 11 or 12 merozoites and clumped
pigment.
The following images show the objects observed on thin smears. We did not include images from thin smears in the case study in order to show that a thick smear can be useful in diagnosing malaria. Based on the images from the thin smear, one can diagnose this as P. vivax. Diagnostic features seen on the thin smear were:
- Large, round gametocyte in enlarged and deformed red blood cell (1.5 to 2.0×). Schüffner's dots were also visible in the RBC.
- Ring form with large chromatin dot and Schüffner's dots in the enlarged RBC (1.5×).
- Large schizont, with approximately 17 or 18 merozoites, in an enlarged RBC (1.5×)with Schüffner's dots.
|
 |
| A | B |
|
| C |
For more information about P. vivax, please click here, navigate to Diagnostic Findings, and click on the Comparison of Plasmodium Species to go to a table listing the primary four species of Plasmodium that infect humans.